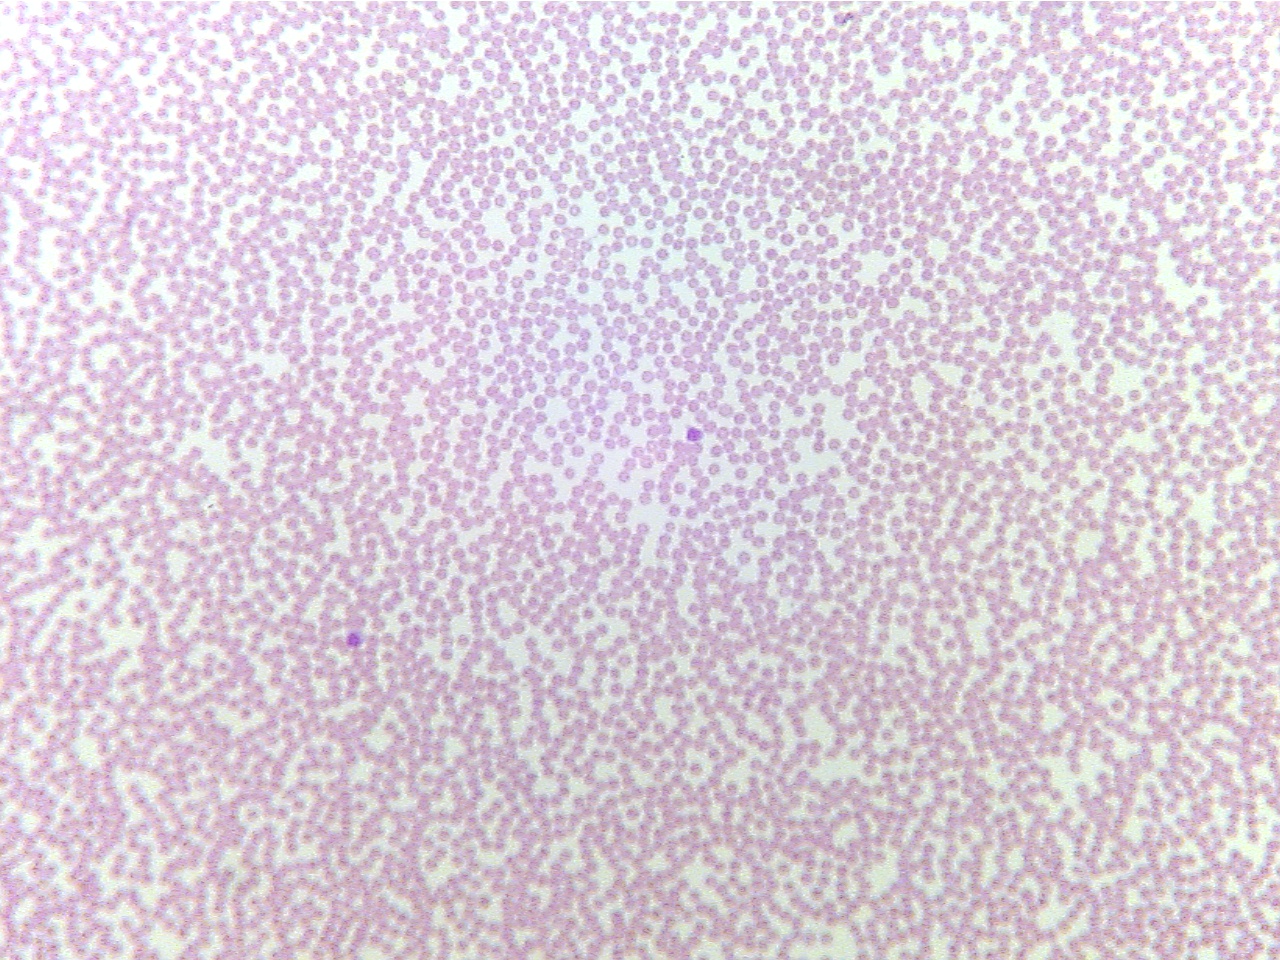
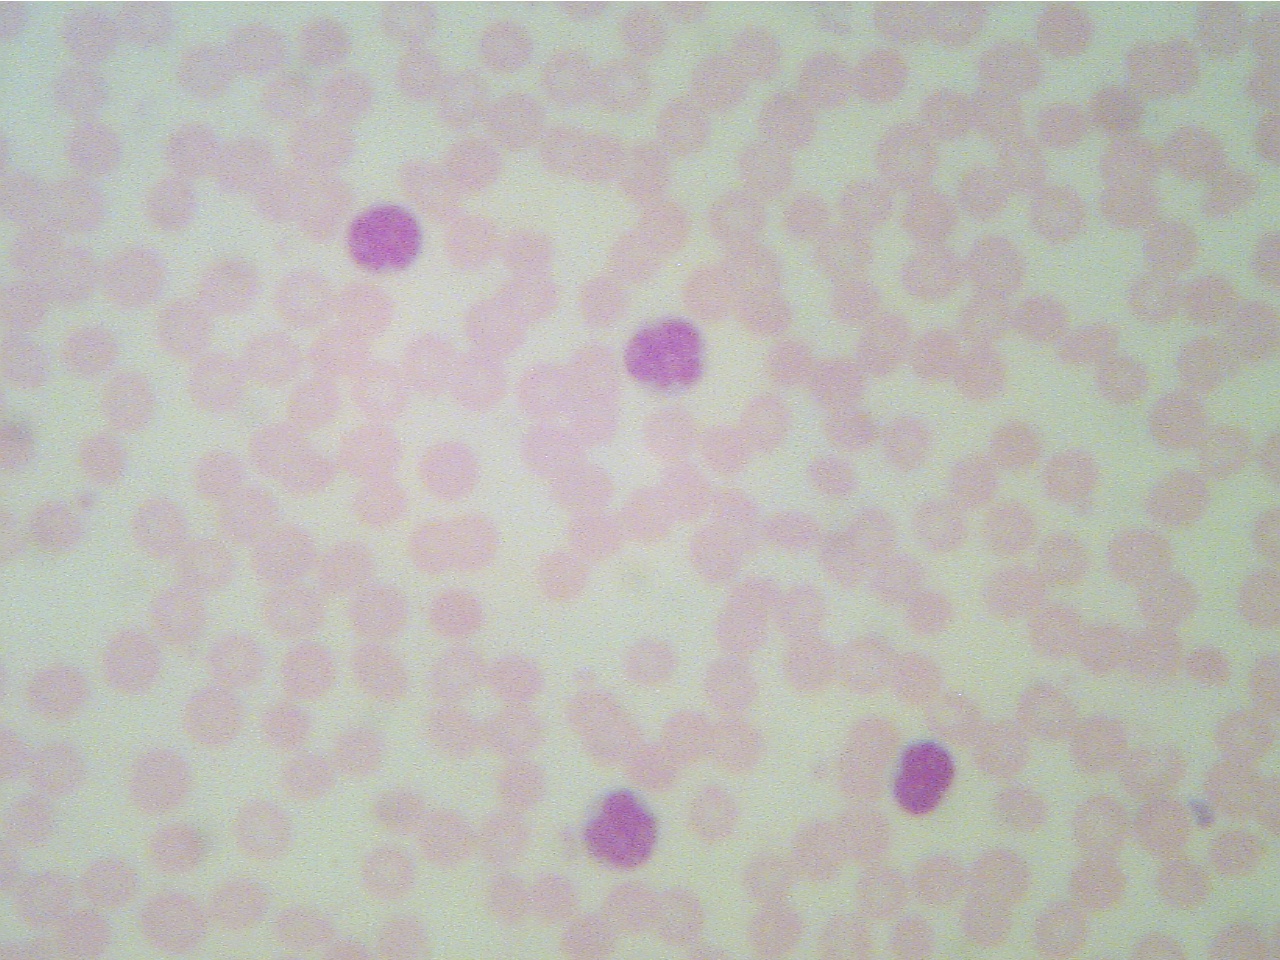
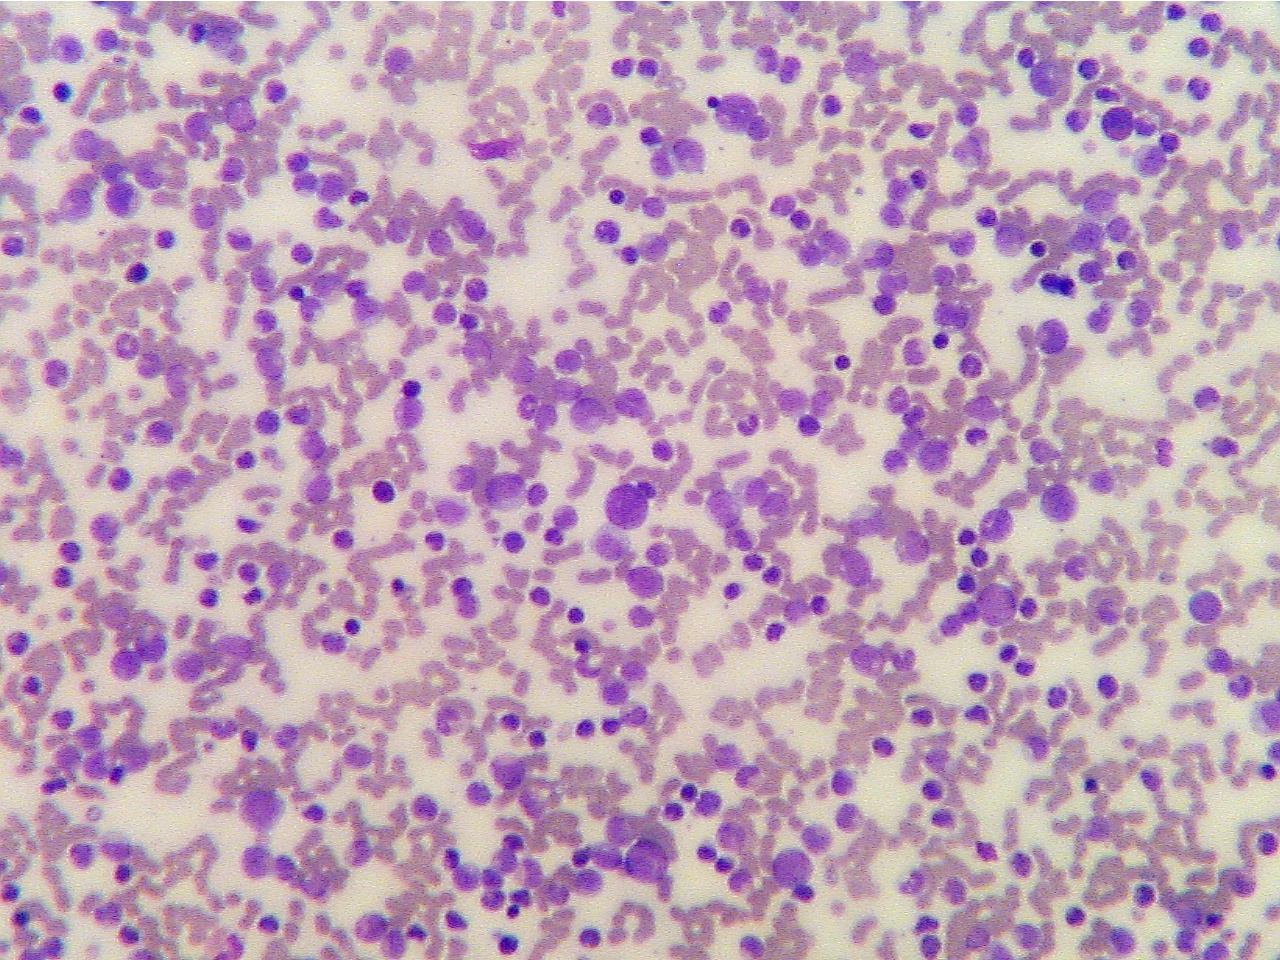
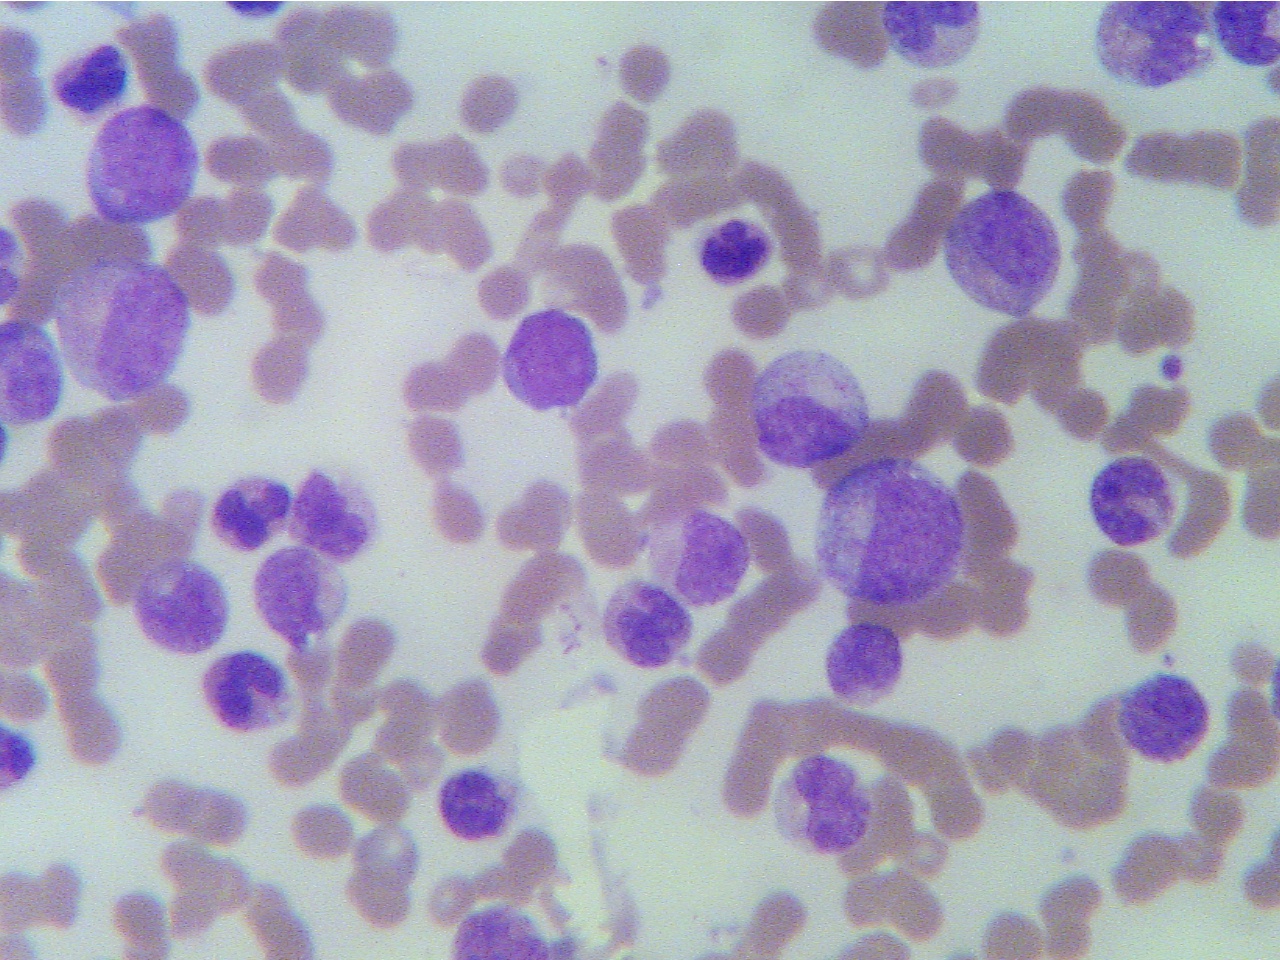

Normal blood (100X2.0) Normal blood - WBCs are dark (100X2.8)

Two WBCs (blue dots) and many RBCs TwoWBCs (lymphocyte at left, neutrophil at far right)
and many RBCs
Now study the smear from a patient with chronic lymphocytic leukemia. Note the relative abundance of RBCs and WBCs (observing a number of fields) and note that almost all the WBCs are lymphocytes.
Lymphocytic leukemia (100X2.0) Lymphocytic leukemia (400X2.3)

Many WBCs (dark dots), which are lymphoctes Four WBCs, all of which are lymphocytes
On the slide of the chronic granulocytic leukemia, note that there are more WBCs than RBCs and that the WBCs are abnormal in size, shape and nuclei. Compare these WBCs with those in the normal blood smear.
Granulocytic leukemia (100X2.8) Granulocytic leukemia (400X2.3)

WBCs (blue cells) are extremely numerous, RBCs are WBCs (blue cells) are numerous and many are dysplastic
much less numerous than in normal blood (i.e., have abnormal stucture {e.g., abnormally large, large
nuclei})
* What is a general term for a cancer involving WBCs? (pp. 116-117 96)